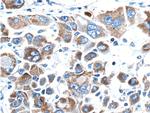
MEKK3 Antibody in Immunohistochemistry (Paraffin) (IHC (P))

Search
Proteintech
MEKK3 Polyclonal Antibody
{{$productOrderCtrl.translations['antibody.pdp.commerceCard.promotion.promotions']}}
{{$productOrderCtrl.translations['antibody.pdp.commerceCard.promotion.viewpromo']}}
{{$productOrderCtrl.translations['antibody.pdp.commerceCard.promotion.promocode']}}: {{promo.promoCode}} {{promo.promoTitle}} {{promo.promoDescription}}. {{$productOrderCtrl.translations['antibody.pdp.commerceCard.promotion.learnmore']}}
产品信息
21072-1-AP
种属反应
已发表种属
宿主/亚型
分类
类型
抗原
偶联物
形式
浓度
规格
纯化类型
保存液
内含物
保存条件
运输条件
产品详细信息
Immunogen sequence: VSVHHKDYS DGRRTFPRIR RHQGNLFTLV PSSRSLSTNG ENMGLAVQYL DPRGRLRSAD SENALSVQER NVPTKSPSAP INWRRGK (281-366 aa encoded by BC090859 )
靶标信息
MAP3K3 (MEKK3) directly regulates MAPK8 and extracellular signal-regulated protein kinase (ERK) pathways by phosphorylating multiple MAP2Ks. Northern blot analysis revealed a 4. 6-kb transcript that appears to be ubiquitously expressed. This protein directly regulates the stress-activated protein kinase (SAPK) and extracellular signal-regulated protein kinase (ERK) pathways by activating SEK and MEK1/2 respectively; it does not regulate the p38 pathway. In cotransfection assays, it enhanced transcription from a nuclear factor kappa-B (NFKB)-dependent reporter gene, consistent with a role in the SAPK pathway. Alternatively spliced transcript variants encoding distinct isoforms have been observed.
仅用于科研。不用于诊断过程。未经明确授权不得转售。
生物信息学
蛋白别名: MAP/ERK kinase kinase 3; MAPK/ERK kinase kinase 3; MEK kinase 3; MEKK 3; Mitogen-activated protein kinase kinase kinase 3; unnamed protein product
基因别名: CCM5; MAP3K3; MAPKKK3; MEKK3
UniProt ID: (Human) Q99759
Entrez Gene ID: (Human) 4215